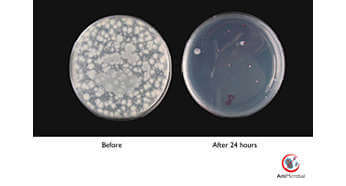
بدنه آنتی باکتریال

مانیتور C271P4QPJEW فیلیپس،27 اینچی با رزولوشن 1920×1080 است. با استفاده از پنل های LCD با کیفیت و با تکنولوژی LED، فیلیپس محصولی قابلاطمینان و با قیمت مناسب عرضه کرده که برای مصارف پزشکی ایده آل است. تصاویر grayscale پزشکی در مانیتورهای معمولی اکثرا دارای کیفیت بالایی نیستند بنابراین استفاده از آنها در محیط های کلینیکی مناسب نیست ولی مانیتورهای clinical review فیلیپس با تنظیم clinical D-image در کارخانه کالیبره شدهاند تا نمایش grayscale سازگار با استاندارد DICOM عرضه کنند.

این مانیتور دارای بدنه آنتی باکتریال است که رشد میکروب ها را مهار میکند. در بدنه این مانیتوراز افزودنی آنتیباکتریال JIS Z2801 استفاده شده که جلوی رشد جانوران میکروسکوپی را میگیرد و بدین ترتیب سلامت بیماران و کارکنان تضمین میشود.
AMVA LED برای تصاویر عریض با وضوح و کنتراست بالا: این مانیتور نه تنها کارهای معمول اداری را به سادگی انجام میدهد، بطور خاص برای عکس، فیلم، بازی، مرور وب و کاربردهای گرافیکی بسیار مناسب است. این مانیتور با استفاده از تکنولوژی انحصاری smart image محتویات تصویر را آنالیز میکند و بر اساس کاربردها یا تصاویر متفاوتِ نمایش داده شده در صفحه، محتویات آن را با تنظیم روشنایی، کنتراست، رنگ و... بهینه میکند.

منبع تغذیه medical grade، ایمنی بالا را با emission پایین فراهم می کند: برخلاف مانیتورهای معمولی این مانیتورها از استاندارد EN/IEC 60601-1 و همچنین استاندارد جنبی 60601-1-2 برای تامین امنیت و کارایی لازم تبعیت میکنند که رعایت این استانداردها در خیلی از بیمارستانها الزامی است.
Powersensor تا 80% باعث صرفه جویی در مصرف انرژی می شود: این سنسور با استفاده از ارسال و دریافت سیگنال های بی ضرر فروسرخ، حضور کاربر را مشخص می کند و وقتی کاربر حاضر نباشد، بطور اتوماتیک نور صفحه را کم میکند که موجب افزایش عمر مانیتور نیز میشود.

پایه smartergo که در این مانیتورها استفاده شده به کاربر اجازه میدهد که مانیتور را در راحتترین و مناسبترین موقعیت نسبت به خود قرار دهد و ارتفاع آن را به دلخواه و با توجه به قد خود تنظیم کند. همچنین این پایه امکان مرتب کردن کابلها را برای کاربر فراهم میکند.
این مانیتور دارای رابط HDMI است که به راحتی امکان انتقال اطلاعات صوتی و تصویری را میسر میکند. همچنین دارای 4 پورت USB.2 و اسپیکرهای داخلی باکیفیت است. Display port (که یک لینک دیجیتال بین PC و مانیتور است) در این مانیتور تا 15 متر کابل و سرعت انتقال اطلاعات تا 10.8 Gbps/sec را ساپورت میکند.
فارسی
العربية
Chinese
English
